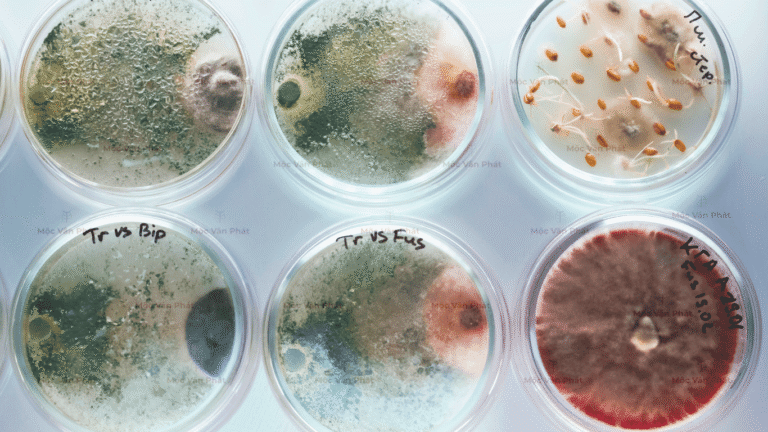
nấm_trichoderma

Hiểu rõ nấm Trichoderma có tác dụng gì đối với nền trồng sạch?

Một nền giá thể trồng cây tốt không chỉ đơn thuần là sạch rác hay tạp chất.
Nó còn cần một hệ vi sinh vật có lợi để chủ động bảo vệ bộ rễ khỏi các tác nhân gây hại.
Trong các công thức giá thể cao cấp, nấm Trichoderma có tác dụng gì khi được trộn cùng xơ dừa, trấu hun và đá Perlite?
Tại Mộc Vân Phát, chúng tôi đưa loại nấm này vào như một “tuyến phòng thủ tự nhiên”, giúp nền trồng vừa thông thoáng vừa có khả năng kháng bệnh chủ động.
Bản chất đối kháng của nấm Trichoderma có tác dụng gì?
Để trả lời câu hỏi nấm Trichoderma có tác dụng gì, bạn cần biết đây là một loại nấm đối kháng cực mạnh.
Khi xuất hiện trong giá thể, chúng sẽ thiết lập một hệ thống kiểm soát, ức chế sự phát triển của các loại nấm ký sinh gây thối rễ như Fusarium hay Pythium.
Sự hiện diện của “vi sinh cảnh sát” này giúp bảo vệ những đầu rễ non nớt khỏi sự tấn công của mầm bệnh từ môi trường bên ngoài.
Khả năng phân hủy hữu cơ của nấm Trichoderma có tác dụng gì?

Không chỉ dừng lại ở việc bảo vệ, nấm Trichoderma có tác dụng gì trong việc cải tạo cấu trúc giá thể?
Khi được trộn trực tiếp vào mụn dừa và xơ dừa, chúng tiết ra các enzyme giúp phân hủy nhanh các chất xơ khó tiêu, giải phóng nguồn dinh dưỡng tự nhiên cho cây hấp thụ.
Tại Mộc Vân Phát, đây là chìa khóa giúp giá thể luôn giàu năng lượng và duy trì độ tơi xốp bền bỉ.
Mật độ vi sinh của nấm Trichoderma có tác dụng gì đến hiệu quả?

Hiệu quả của nấm Trichoderma có tác dụng gì phụ thuộc rất lớn vào mật độ bào tử.
Mộc Vân Phát ưu tiên lựa chọn những dòng nấm có mật độ vi sinh cao để đảm bảo hệ vi sinh trong giá thể hoạt động ổn định nhất.
Một mật độ đủ lớn sẽ giúp nấm chiếm lĩnh không gian sống nhanh chóng, không cho nấm hại có cơ hội xâm nhập vào vùng rễ cây.
Kết quả thực tế: Nấm Trichoderma có tác dụng gì cho bộ rễ trắng khỏe?

Quan sát thực tế trên cùng một nhóm cây và thời gian gieo trồng, bạn sẽ thấy rõ nấm Trichoderma có tác dụng gì?
Những chậu cây không có vi sinh bảo vệ thường có bộ rễ bị thâm, dễ thối khi dư ẩm.
Ngược lại, giá thể có Trichoderma luôn cho bộ rễ trắng muốt và vươn dài.
Đó là minh chứng cho một hệ sinh thái giá thể khỏe mạnh mà Mộc Vân Phát luôn hướng tới.
Mộc Vân Phát – Kiến tạo hệ sinh thái từ nấm Trichoderma
Tại Mộc Vân Phát, chúng tôi không chỉ trộn đất thông thường.
Chúng tôi xây dựng một hệ sinh thái giá thể hoàn chỉnh để cây trồng của bạn có thể bắt đầu từ một bộ rễ vững vàng nhất.
Việc ứng dụng nấm Trichoderma vào quy trình sản xuất chính là sự tử tế của chúng tôi dành cho từng mầm xanh của khách hàng.
